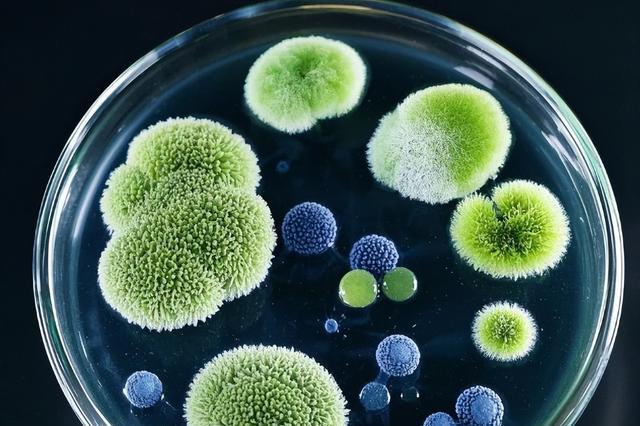

前言
玩过生化游戏的都知道,被病毒感染的僵尸多吓人,大脑被控制,沦为傀儡。
但你敢信吗?现实里还真有类似“操控大师”,不是病毒,而是没心没脑的真菌!
它能把蚂蚁变成“僵尸”,却连人类的脚气都搞不定。
这真菌到底是啥“双面怪物”?
没大脑还能“思考”?
提起真菌,多数人第一反应是蘑菇、脚气,但这东西的神奇程度,游戏策划都不敢这么编。
它没有心脏和大脑,按说连基本的“反应”都该没有,可偏偏能搞出一堆超纲操作。
首先是“学习+记忆+交流”三件套。
科学家观察到,真菌的菌丝网络就像一张隐形的“信息网”,不同菌丝之间能传递信号,甚至能记住之前接触过的环境,简直是“无脑智者”。
更绝的是它的“精准定位”能力。
真菌找生存位置时,能准确找到叶子上最适合附着的地方,甚至能判断宿主的弱点。
但到底靠啥感知?至今没完全搞明白。
不过也别担心,这货在人类面前就是“纸老虎”。它想入侵人体?基本没戏。
人类体温36℃左右,对真菌来说就是“高温地狱”,稍微发烧就能让它直接“原地去世”。
唯一能让它得逞的,也就只有脚部。
因为脚的温度是全身最低的,再加上穿鞋闷出的潮气,刚好给真菌留了个空子,这就是脚气的由来。
只欺负“软柿子”?
别看真菌在人类这儿讨不到好,在昆虫界那可是“顶级反派”,尤其擅长把无脊椎动物变成“僵尸傀儡”。
为啥只找昆虫麻烦?答案很简单,昆虫没有复杂大脑,只有原始神经元,操控难度低。
它最经典的操作,就是对付蚂蚁。
一旦蚂蚁被感染,悲剧就开始了:真菌会先控制蚂蚁的神经,让它偏离蚁群,独自爬到植物叶子上,然后死死咬住叶片。
更狠的是“养分掠夺”。真菌会消耗蚂蚁的血糖,让蚂蚁产生强烈的饥饿感,逼着蚂蚁疯狂进食。
但这些吃进去的养分,最后全被真菌吸走了,蚂蚁相当于在“为真菌打工”,哪怕真菌不杀它,蚂蚁也会被活活撑死。
等到蚂蚁没用了,真菌就会从它身体里长出来,释放孢子,等着下一只蚂蚁上钩。
不过昆虫也不是完全没反抗。
有些蚂蚁进化出了“以毒攻毒”的本事,在体内引入一种“重寄生真菌”,专门对付“僵尸真菌”。
相比之下,真菌的生存能力强多了,只要孢子还在,就能换个宿主继续作妖。
人类能高枕无忧吗?
看到这儿,肯定有人问:既然真菌能操控昆虫,万一它进化出耐高温的能力,会不会像游戏里那样操控人类?
答案是基本不可能。 首先,人类大脑太复杂了。
现在已知的真菌感染人类,比如真菌肺炎,也只在人免疫力极低的时候才会爆发,正常情况下,免疫系统分分钟就能把真菌消灭。
其次,进化需要时间。真菌想进化出耐高温、能突破人类免疫系统的能力,少说也得几亿年。
就算有人想人工干预,也很难绕过自然规律,而且人类也不会允许这种危险的研究大规模进行。
更重要的是,人类和真菌其实是“合作共赢”的关系。
除了脚气这点小麻烦,真菌给人类的帮助可不少:比如我们用的青霉素、美白去角质的曲酸,都是从真菌里提取的。
当然,我们也不能完全忽视真菌。随着环境变化,说不定会有新的真菌种类出现,可能会对人类或农作物造成威胁。
但只要我们继续研究真菌的习性,搞清楚它的“弱点”,就能更好地利用它、控制它,让它为人类服务,而不是变成“威胁”。
真菌这东西,既神奇又可怕,没大脑却能“思考”,能操控昆虫却拿人类没办法,既是“反派”也是“帮手”。
它的存在,让我们看到了生命的多样性,比起担心真菌变成“僵尸病毒”,不如多关注它能给我们带来的价值。
未来随着科技发展,我们或许能解锁真菌更多的“技能”!
编辑:陈方
一审:李慧
二审:汤世明
三审:王超